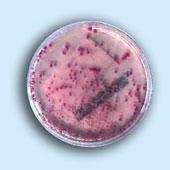

LES CELLULES SOUCHES : des applications cliniques multiples
| La recherche sur les cellules souches, adultes ou embryonnaires, soulève de grands espoirs dans le domaine de la médecine et de la lutte contre le vieillissement et les maladies qui l'accompagnent. L'utilisation des cellules embryonnaires fait l'objet de grands débats d'éthique partout dans le monde et n'est pas autorisée dans tous les pays. Elle est interdite en France. |
|
Les cellules souches humaines ont été isolées, cultivées et différenciées pour la première fois en 1998 sur embryon. Selon leur origine, on en distingue différents types : |
 |
| Les cellules souches adultes
Les cellules souches sont naturellement présentes dans les organes et permettent une régénération des cellules. |
| La recherche sur les cellules souches adultes
Il y a encore peu de temps, on croyait que les cellules souches ne pouvaient être utilisées que pour développer un tissu de type identique à celui dont elles étaient originaires. Ainsi, on pensait que l'on pouvait fabriquer des cellules sanguines uniquement à partir de cellules souches de moelle épinière, de la peau à partir de cellules souches de peau et ainsi de suite. On pensait également que les cellules souches adultes pouvaient être dérivées d'un nombre très limité de sources et qu'elles étaient difficiles à isoler et à développer en culture cellulaire. |
 |
Des études récentes ont ainsi montré que les cellules de la moelle épinière peuvent être transformées en d'autres types de tissus comme des cellules sanguines et qu'elles ont un potentiel pour le traitement de toute une variété de maladies. |
|
Dans une autre étude au Collège Médical de New-York, des scientifiques ont injecté des cellules de moelle épinière de souris donneuses dans la paroi contractile du cœur de souris réceptrices qui avait été endommagé par ischémie. Après neuf jours, ils ont trouvé des tissus cardiaques nouvellement formés dans 68% des infarctus. |
| Les cellules souches embryonnaires
Au niveau mondial, le développement des recherches sur les cellules souches embryonnaires est considérable. |
|
Après fécondation, la cellule issue de la fusion du gamète mâle (spermatozoïde) et femelle (ovocyte) se divise en deux cellules (stade 2), puis en quatre cellules (stade 4). |
 |
|
Les cellules souches embryonnaires issues d'un embryon cloné ont un avantage important sur les cellules adultes. Les cellules, les tissus et les organes générés à partir des cellules souches clonées seront immunologiquement pratiquement identiques aux cellules du donneur à partir desquelles l'embryon a été créé. Cela permettrait de les transplanter chez le donneur sans avoir de problèmes de rejet. Il sera également possible de réaliser des modifications génétiques sur ces cellules pour corriger certains défauts. |
|
Actuellement, les transplantations nécessitent généralement l'administration pendant une longue durée de médicaments toxiques et onéreux comme la cyclosporine pour empêcher le rejet du tissu ou de l'organe transplanté. Bien qu'il puisse devenir possible de cultiver des tissus issus de cellules souches adultes provenant de patients spécifiques pouvant ensuite être transplantés dans ces patients sans problème de rejet, cela risque de ne pas marcher aussi bien qu'avec des cellules embryonnaires clonées. |
|
- d'embryons surnuméraires issus de procréation médicalement assistée (fécondation in vitro) et pour lesquels aucun projet parental n'a été maintenu par le couple, |
| La recherche sur les cellules souches embryonnaires
La recherche sur les cellules souches embryonnaires est en retard de près d'une décennie sur celle portant sur les cellules souches adultes. La première démonstration4 que des cellules souches embryonnaires humaines pouvaient être cultivées a été faite à Madison, à l'Université du Wisconsin, à la fin de 1998. Dans cette première publication, la preuve a été faite qu'elles peuvent se différencier en peau, en neurones, en cellules musculaires cardiaques et en toutes les sortes de cellules différentes de l'organisme. Dans ce travail initial, la différenciation était aléatoire. Les cellules étaient autorisées soit à se différencier n'importe comment ou elles étaient injectées à des souris ayant un système immunitaire défaillant. Les souris ne pouvant rejeter les tissus humains à l'intérieur d'elles, les cellules ont grandi en ce que l'on appelle un teratoma qui est un conglomérat de différents types de cellules et de tissus. |
 |
Récemment, des scientifiques de l'Université de Hadassah à Jérusalem ont développé à partir de cellules souches embryonnaires des précurseurs neuraux qui ont ensuite été incités à se développer (in vitro) en neurones matures, astrocytes et oligodendrocytes. Quand5 ces cellules furent transplantées dans les cerveaux de souriceaux nouveau-nés, elles ont migré dans différentes régions en réponse à des directives normales de développement. |
|
Les nouvelles cellules humaines ne se distinguaient pas morphologiquement des cellules des animaux receveurs. Elles pouvaient seulement être détectées en utilisant des marqueurs spécifiques de l'homme. |
| Quel peut être l'impact des recherches sur les cellules souches ?
Les applications cliniques potentielles d'un succès des cultures de cellules souches embryonnaires humaines sont vastes. Une application immédiate est l'évaluation de médicaments. Des lignes de cellules humaines pleinement matures pourraient permettre de tester la toxicité de médicaments sur différents types de tissus. Les cellules embryonnaires humaines cultivées ressemblant à des embryons humains en développement, elles pourraient être utilisées pour identifier les médicaments qui peuvent interférer au cours de la grossesse avec un développement embryonnaire normal. |
Références : 1 Oalmer TD et al., Progenitor cells from human brain after death. Nature, 411:42-43 May 3 (2001) 2 El Oakley RM et al., Myocyte transplantation for cardiac repair: a few good cells can mend a broken heart. Annals of Thoracic Surgery, 71:1724-1733 (2001). 3 Stanworth SJ et al., Stem cells : progress in research and edging towards the clinical setting. Clinical Medicine, 1:5:378-382, Sept/Oct (2001) 4 Thomson JA et al., Embryonic stem cell lines derived from human blastocysts. Science 282:1145-47 (1998) 5 Reubinoff BE et al., Neural progenitors from human embryonic stem cells. Nat Biotechnol, 19:12:1134-1140, Dec (2001) 6 Zhang S-C et al., in vitro differentiation of transportable neural precursors from human embryonic stem cells. Nat Biotechnol. 19:12:1129-1133, Dec (2001). 7 Schuldiner M et al. Induced neuronal differentiation of human embryonic stem cells. Brain Research, 913:2:201-205, sept 21 (2001). |
Tous droits de reproduction réservés
Gratuit
Merci de votre visite, avant de partir
inscrivez-vous auClub SuperSmart
d'avantages exclusifs:
- Gratuit : la publication hebdomadaire scientifique "Nutranews"
- Des promotions exclusives aux membres du club

















